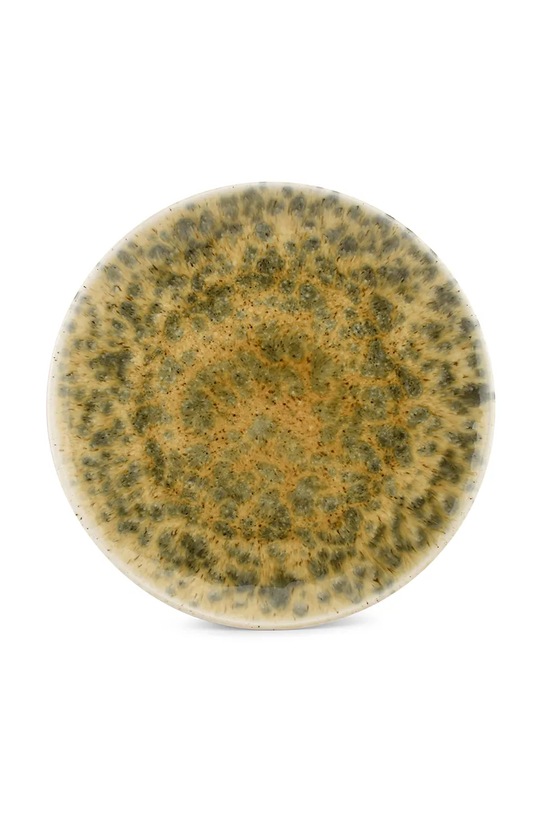

ANSWEAR CLUB
Vásárold meg ezt a terméket az ANSWEAR CLUB-ban. Ismerd meg a szabályokat és vásárolj olcsóbban!
Ingyenes szállítás és visszaküldés (22 000 Ft-tól)
Kiküldés 24 órán belül (öko-csomagban)
Megtakarítás az Answear Club segítségével
- A termék érintkezhet élelmiszerrel.
- Mosogatógépben mosható.
- Mikrohullámú sütőben használható.
- Méretek: 25 cm.
Gyártó
Fine Dining & Living
Herentalseweg 66, 2440 Geel, Belgium
+32 14 24 29 00
info@finedl.eu
A megrendelés kézbesítéséhez a GLS, DPD és FOXPOST-Packeta Group futárszolgálatot használjuk.
Az ANSWEAR.hu ügyfeleinek ingyenes szállítást kínál Magyarország területén minden olyan rendelés esetében, amelynek értéke azonos, vagy meghaladja a 22 000 Ft összeget. Kivételt képez ez alól a GLS futárszolgálat igénybevétele.
Amennyiben DPD vagy FOXPOST-Packeta Group futárszolgálatot veszed igénybe és a rendelés értéke nem haladja meg a 22 000 Ft-ot, úgy szállítási költséget számolunk fel, ennek az összege 1690 Ft FOXPOST-Packeta Group esetében és 1790 DPD esetében.
GLS futárszolgálat igénybe vétele esetén, amennyiben a rendelés értéke nem haladja meg a 22 000 Ft-ot, a szállítási költség 2140 Ft, amennyiben meghaladja, a szállítás költsége 350 Ft.
További információ ITT
Szeretnél terméket visszaküldeni? Mi sem egyszerűbb! A vásárlást követően 30 nap áll rendelkezésedre indoklás nélkül.
Ha regisztrált vásárlónk vagy és a rendelésed értéke eléri vagy meghaladja a 22 000 Ft-ot, akkor igénybe veheted az ingyenes visszáru szolgáltatásunkat. További információ ITT
Reklamáció? Az Áruházban vásárolt összes termék szavatossági ideje 2 év, melynek kezdő időpontja az áru vevő általi átvételével kezdődik, összhangban a Fogyasztói törvénnyel. A teljes reklamációs folyamat leírása ITT